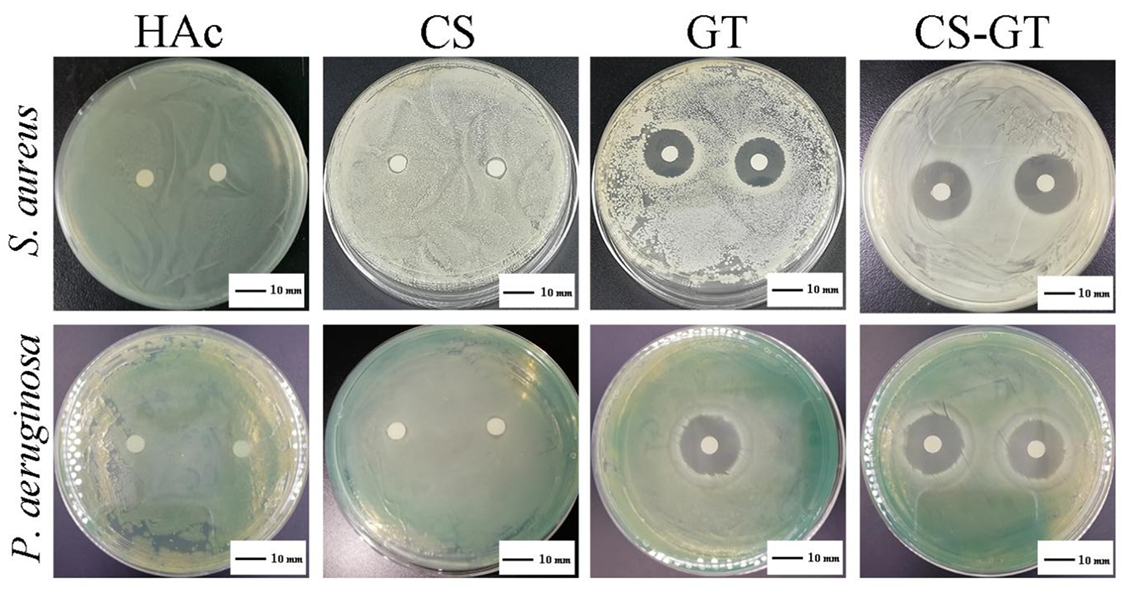
Marinedrugs 18 00233 g001

Chitosan-Gentamicin Conjugate Hydrogel Promoting Skin Scald Repair
Abstract
1. Introduction
2. Results and Discussion
2.1. Antibacterial Activity
2.2. Cell Viability
2.3. Hemolysis Assay
2.4. Wound Macroscopy and Healing Rates
2.5. Histological Observation
2.6. TP and HYP Contents in Granulation Tissue
2.7. Expression of Proinflammatory Factors
3. Materials and Methods
3.1. Experimental Materials
3.2. Experimental Materials
3.3. Preparation of CS-GT Hydrogel
3.4. In Vitro Antibacterial Assay
3.5. In Vitro Cytotoxicity Study
3.6. Hemolysis Assay
3.7. In Vivo Animal Test
3.8. Histological Observation
3.9. Determination of TP Content and Proinflammatory Cytokine Levels
3.10. Determination of HYP
3.11. Statistical Analysis
4. Conclusions
Author Contributions
Funding
Conflicts of Interest
References
- Wells, A.; Nuschke, A.; Yates, C.C. Skin tissue repair: Matrix microenvironmental influences. Matrix Biol. 2016, 49, 25–36. [Google Scholar] [CrossRef]
- Singh, N.P.; Rani, M.; Gupta, K.; Sagar, T.; Kaur, I.R. Changing trends in antimicrobial susceptibility pattern of bacterial isolates in a burn unit. Burns 2017, 43, 1083–1087. [Google Scholar] [CrossRef] [PubMed]
- Ross, R.B.E. Wound healing and collagen formation. II. Fine structure inexperimental scurvy. J. Cell Biol. 1962, 12, 533–551. [Google Scholar] [CrossRef]
- Wang, Z.; Zhang, H.; Han, J.; Xing, H.; Wu, M.C.; Yang, T. Deadly Sins of Antibiotic Abuse in China. Infect. Cont. Hosp. Epidemiol. 2017, 38, 758–759. [Google Scholar] [CrossRef][Green Version]
- Nishio, N.; Okawa, Y.; Sakurai, H.; Isobe, K. Neutrophil depletion delays wound repair in aged mice. Age 2008, 30, 11–19. [Google Scholar] [CrossRef]
- Rashaan, Z.M.; Krijnen, P.; Kwa, K.A.A.; van der Vlies, C.H.; Schipper, I.B.; Breederveld, R.S. Flaminal(R) versus Flamazine(R) in the treatment of partial thickness burns: A randomized controlled trial on clinical effectiveness and scar quality (FLAM study). Wound Repair Regen. 2019, 27, 257–267. [Google Scholar] [CrossRef] [PubMed]
- Patel, S.; Srivastava, S.; Singh, M.R.; Singh, D. Preparation and optimization of chitosan-gelatin films for sustained delivery of lupeol for wound healing. Int. J. Biol. Macromol. 2018, 107, 1888–1897. [Google Scholar] [CrossRef] [PubMed]
- Sahu, S.A.; Agrawal, K.; Patel, P.K. Scald burn, a preventable injury: Analysis of 4306 patients from a major tertiary care center. Burns 2016, 42, 1844–1849. [Google Scholar] [CrossRef]
- Bano, I.; Arshad, M.; Yasin, T.; Ghauri, M.A. Preparation, characterization and evaluation of glycerol plasticized chitosan/PVA blends for burn wounds. Int. J. Biol. Macromol. 2019, 124, 155–162. [Google Scholar] [CrossRef]
- Guadalupe, E.; Ramos, D.; Shelke, N.B.; James, R.; Gibney, C.; Kumbar, S.G. Bioactive polymeric nanofiber matrices for skin regeneration. J. Appl. Polym. Sci. 2015, 132, 1–10. [Google Scholar] [CrossRef]
- Hu, S.; Cai, X.; Qu, X.; Yu, B.; Yan, C.; Yang, J.; Li, F.; Zheng, Y.; Shi, X. Preparation of biocompatible wound dressings with long-term antimicrobial activity through covalent bonding of antibiotic agents to natural polymers. Int. J. Biolog. Macromol. 2019, 123, 1320–1330. [Google Scholar] [CrossRef] [PubMed]
- Hajiali, H.; Summa, M.; Russo, D.; Armirotti, A.; Brunetti, V.; Bertorelli, R.; Athanassiou, A.; Mele, E. Alginate–lavender nanofibers with antibacterial and anti-inflammatory activity to effectively promote burn healing. J. Mater. Chem. B 2016, 4, 1686–1695. [Google Scholar] [CrossRef] [PubMed]
- Gao, Y.; Zhang, X.; Jin, X. Preparation and Properties of Minocycline-Loaded Carboxymethyl Chitosan Gel/Alginate Nonwovens Composite Wound Dressings. Mar. Drugs 2019, 17, 575. [Google Scholar] [CrossRef] [PubMed]
- Sajomsang, W.; Gonil, P.; Tantayanon, S. Antibacterial activity of quaternary ammonium chitosan containing mono or disaccharide moieties: Preparation and characterization. Int. J. Biol. Macromol. 2009, 44, 419–427. [Google Scholar] [CrossRef]
- Aranaz, I.; Mengíbar, M.; Harris, R.; Paños, I.; Miralles, B.; Acosta, N.; Galed, G.; Heras, Á. Functional Characterization of Chitin and Chitosan. Curr. Chem. Biolog. 2009, 3, 203–230. [Google Scholar]
- Cazón, P.; Velazquez, G.; Ramírez, J.A.; Vázquez, M. Polysaccharide-based films and coatings for food packaging: A review. Food Hydrocoll. 2017, 68, 136–148. [Google Scholar] [CrossRef]
- Chabala, L.F.G.; Cuartas, C.E.E.; Lopez, M.E.L. Release Behavior and Antibacterial Activity of Chitosan/Alginate Blends with Aloe vera and Silver Nanoparticles. Mar. Drugs 2017, 15, 1–13. [Google Scholar]
- Xia, G.; Liu, Y.; Tian, M.; Gao, P.; Bao, Z.; Bai, X.; Yu, X.; Lang, X.; Hu, S.; Chen, X. Nanoparticles/thermosensitive hydrogel reinforced with chitin whiskers as a wound dressing for treating chronic wounds. J. Mater. Chem. B 2017, 5, 3172–3185. [Google Scholar] [CrossRef]
- Joraholmen, M.W.; Bhargava, A.; Julin, K.; Johannessen, M.; Skalko-Basnet, N. The Antimicrobial Properties of Chitosan Can be Tailored by Formulation. Mar. Drugs 2020, 18, 96. [Google Scholar] [CrossRef]
- Wang, C.; Luo, W.; Li, P.; Li, S.; Yang, Z.; Hu, Z.; Liu, Y.; Ao, N. Preparation and evaluation of chitosan/alginate porous microspheres/Bletillastriata polysaccharide composite hemostatic sponges. Carbohyd. Polym. 2017, 174, 432–442. [Google Scholar] [CrossRef]
- Rudyardjo, D.I.; Wijayanto, S. The synthesis and characterization of hydrogel chitosan-alginate with the addition of plasticizer lauric acid for wound dressing application. J. Phys. Conf. Ser. 2017, 853, 1–7. [Google Scholar] [CrossRef]
- Ito, T.; Fraser, I.P.; Yeo, Y.; Highley, C.B.; Bellas, E.; Kohane, D.S. Anti-inflammatory function of an in situ cross-linkable conjugate hydrogel of hyaluronic acid and dexamethasone. Biomaterials 2007, 28, 1778–1786. [Google Scholar] [CrossRef]
- Luo, Y.; Diao, H.; Xia, S.; Dong, L.; Chen, J.; Zhang, J. A physiologically active polysaccharide hydrogel promotes wound healing. J. Biomed. Mater. Res. A 2010, 94, 193–204. [Google Scholar] [CrossRef] [PubMed]
- Chang, H.I.; Perrie, Y.; Coombes, A.G.A. Delivery of the antibiotic gentamicin sulphate from precipitation cast matrices of polycaprolactone. J. Control. Release 2006, 110, 414–421. [Google Scholar] [CrossRef] [PubMed]
- Iannuccelli, V.; Maretti, E.; Bellini, A.; Malferrari, D.; Ori, G.; Montorsi, M.; Bondi, M.; Truzzi, E.; Leo, E. Organo-modified bentonite for gentamicin topical application: Interlayer structure and in vivo skin permeation. Appl. Clay Sci. 2018, 158, 158–168. [Google Scholar] [CrossRef]
- Balakumar, P.; Rohilla, A.; Thangathirupathi, A. Gentamicin-induced nephrotoxicity: Do we have a promising therapeutic approach to blunt it? Pharmacol. Res. 2010, 62, 179–186. [Google Scholar] [CrossRef]
- Forge, A.; Li, L. Apoptotic death of hair cells in mammalian vestibular sensory epithelia. Hearing Res. 2000, 139, 97–115. [Google Scholar] [CrossRef]
- Ji, J.; Hao, S.; Wu, D.; Huang, R.; Xu, Y. Preparation, characterization and in vitro release of chitosan nanoparticles loaded with gentamicin and salicylic acid. Carbohyd. Polym. 2011, 85, 803–808. [Google Scholar] [CrossRef]
- Monteiro, N.; Martins, M.; Martins, A.; Fonseca, N.A.; Moreira, J.N.; Reis, R.L.; Neves, N.M. Antibacterial activity of chitosan nanofiber meshes with liposomes immobilized releasing gentamicin. Acta Biomater. 2015, 18, 196–205. [Google Scholar] [CrossRef]
- Zalavras, C.G.; Patzakis, M.J.; Holtom, P. Local Antibiotic Therapy in the Treatment of Open Fractures and Osteomyelitis. Clin. Orthop. Relat. Res. 2004, 86–93. [Google Scholar] [CrossRef]
- Yan, T.; Li, C.; Ouyang, Q.; Zhang, D.; Zhong, Q.; Li, P.; Li, S.; Yang, Z.; Wang, T.; Zhao, Q. Synthesis of gentamicin-grafted-chitosan with improved solubility and antibacterial activity. React. Funct. Polym. 2019, 137, 38–45. [Google Scholar] [CrossRef]
- Xue, H.; Hu, L.; Xiong, Y.; Zhu, X.; Wei, C.; Cao, F.; Zhou, W.; Sun, Y.; Endo, Y.; Liu, M.; et al. Quaternized chitosan-Matrigel-polyacrylamide hydrogels as wound dressing for wound repair and regeneration. Carbohyd. Polym. 2019, 226, 115302. [Google Scholar] [CrossRef] [PubMed]
- Goushbolagh, N.A.; Keshavarz, M.; Zare, M.H.; Bahreyni-Toosi, M.H.; Kargar, M.; Farhood, B. Photosensitizer effects of MWCNTs-COOH particles on CT26 fibroblastic cells exposed to laser irradiation. Artif. Cells Nanomed. Biotechnol. 2019, 47, 1326–1334. [Google Scholar] [CrossRef] [PubMed]
- Roy, A.; Joshi, M.; Butola, B.S.; Ghosh, S. Evaluation of biological and cytocompatible properties in nano silver-clay based polyethylene nanocomposites. J. Hazard. Mater. 2019, 384, 121309. [Google Scholar] [CrossRef] [PubMed]
- Huang, Y.; Ding, X.; Qi, Y.; Yu, B.; Xu, F.J. Reduction-responsive multifunctional hyperbranchedpolyaminoglycosides with excellent antibacterial activity, biocompatibility and gene transfection capability. Biomaterials 2016, 106, 134–143. [Google Scholar] [CrossRef] [PubMed]
- Zheng, C.; Liu, C.; Chen, H.; Wang, N.; Liu, X.; Sun, G.; Qiao, W. Effective wound dressing based on Poly (vinyl alcohol)/Dextran-aldehyde composite hydrogel. Int. J. Biol. Macromol. 2019, 132, 1098–1105. [Google Scholar] [CrossRef]
- Liu, J.Y.; Li, Y.; Hu, Y.; Cheng, G.; Ye, E.; Shen, C.; Xu, F.J. Hemostatic porous sponges of cross-linked hyaluronic acid/cationized dextran by one self-foaming process. Mater. Sci. Eng. C Mater. Biol. Appl. 2018, 83, 160–168. [Google Scholar] [CrossRef]
- Kulshrestha, S.; Chawla, R.; Alam, M.T.; Adhikari, J.S.; Basu, M. Efficacy and dermal toxicity analysis of Sildenafil citrate based topical hydrogel formulation against traumatic wounds. Biomed. Pharmacother. 2019, 112, 128571. [Google Scholar] [CrossRef]
- Liang, Y.; Zhao, X.; Hu, T.; Chen, B.; Yin, Z.; Ma, P.X.; Guo, B. Adhesive Hemostatic Conducting Injectable Composite Hydrogels with Sustained Drug Release and Photothermal Antibacterial Activity to Promote Full-Thickness Skin Regeneration During Wound Healing. Small 2019, 15, 1–17. [Google Scholar] [CrossRef]
- Strassberg, S.S.; Cristea, I.A.; Qian, D.; Parton, L.A. Single nucleotide polymorphisms of tumor necrosis factor-alpha and the susceptibility to bronchopulmonary dysplasia. Pediatr. Pulm. 2007, 42, 29–36. [Google Scholar] [CrossRef]
- Huusko, J.M.; Karjalainen, M.K.; Mahlman, M.; Haataja, R.; Kari, M.A.; Andersson, S.; Toldi, G.; Tammela, O.; Rämet, M. A study of genes encoding cytokines (IL6, IL10, TNF), cytokine receptors (IL6R, IL6ST), and glucocorticoid receptor (NR3C1) and susceptibility to bronchopulmonary dysplasia. BMC Medical Genet. 2014, 15, 1–9. [Google Scholar] [CrossRef] [PubMed]
- Prasad, R.; Kapoor, R.; Srivastava, R.; Mishra, O.P.; Singh, T.B. Cerebrospinal fluid TNF-alpha, IL-6, and IL-8 in children with bacterial meningitis. Pediatr. Neurol. 2014, 50, 60–65. [Google Scholar] [CrossRef] [PubMed]
- Pujji, O.J.S.; Nakarmi, K.K.; Shrestha, B.; Rai, S.M.; Jeffery, S.L.A. The Bacteriological Profile of Burn Wound Infections at a Tertiary Burns Center in Nepal. J. Burn. Care. Res. 2019, 40, 838–845. [Google Scholar] [CrossRef] [PubMed]
- Wang, X.; Deng, A.; Cao, W.; Li, Q.; Wang, L.; Zhou, J.; Hu, B.; Xing, X. Synthesis of chitosan/poly (ethylene glycol)-modified magnetic nanoparticles for antibiotic delivery and their enhanced anti-biofilm activity in the presence of magnetic field. J. Mater. Sci. 2018, 53, 6433–6449. [Google Scholar] [CrossRef]
- Feng, C.; Li, J.; Wu, G.S.; Mu, Y.Z.; Kong, M.; Jiang, C.Q.; Cheng, X.J.; Liu, Y.; Chen, X.G. Chitosan-Coated Diatom Silica as Hemostatic Agent for Hemorrhage Control. ACS Appl. Mater. Interfaces 2016, 8, 34234–34243. [Google Scholar] [CrossRef]
- Zhu, M.; Liu, P.; Shi, H.; Tian, Y.; Ju, X.; Jiang, S.; Li, Z.; Wu, M.; Niu, Z. Balancing antimicrobial activity with biological safety: Bifunctional chitosan derivative for the repair of wounds with Gram-positive bacterial infections. J. Mater. Chem. B 2018, 6, 3884–3893. [Google Scholar] [CrossRef]

| Test strain | CS | GT | CS-GT |
|---|---|---|---|
| S. aureus | 7.0 ± 1.0 | 17.7 ± 1.2 * | 20.0 ± 1.0 *,# |
| P. aeruginosa | 7.0 ± 1.0 | 21.3 ± 0.6 * | 20.3 ± 0.6 * |
| Time/d | Blank | Matrix | Positive | GT | CS-GT |
|---|---|---|---|---|---|
| 3 | −6.67 ± 9.31 | −1.81 ± 7.78 | 3.72 ± 2.10 | 20.12 ± 7.46 ** | 15.10 ± 8.82 * |
| 7 | 11.88 ± 6.63 | 19.15 ± 10.03 | 24.68 ± 12.92 | 39.7 ± 5.24 | 31.57 ± 12.02 |
| 14 | 55.88 ± 7.07 | 58.26 ± 6.99 | 76.86 ± 6.34 | 66.24 ± 8.59 | 89.18 ± 11.75 * |
| 21 | 75.45 ± 2.17 | 77.39 ± 0.67 | 94.98 ± 0.40* | 87.50 ± 2.09 * | 99.61 ± 0.23 ** |
© 2020 by the authors. Licensee MDPI, Basel, Switzerland. This article is an open access article distributed under the terms and conditions of the Creative Commons Attribution (CC BY) license (http://creativecommons.org/licenses/by/4.0/).
Share and Cite
Yan, T.; Kong, S.; Ouyang, Q.; Li, C.; Hou, T.; Chen, Y.; Li, S. Chitosan-Gentamicin Conjugate Hydrogel Promoting Skin Scald Repair. Mar. Drugs 2020, 18, 233. https://doi.org/10.3390/md18050233
Yan T, Kong S, Ouyang Q, Li C, Hou T, Chen Y, Li S. Chitosan-Gentamicin Conjugate Hydrogel Promoting Skin Scald Repair. Marine Drugs. 2020; 18(5):233. https://doi.org/10.3390/md18050233
Chicago/Turabian StyleYan, Tingting, Songzhi Kong, Qianqian Ouyang, Chengpeng Li, Tingting Hou, Yu Chen, and Sidong Li. 2020. "Chitosan-Gentamicin Conjugate Hydrogel Promoting Skin Scald Repair" Marine Drugs 18, no. 5: 233. https://doi.org/10.3390/md18050233
APA StyleYan, T., Kong, S., Ouyang, Q., Li, C., Hou, T., Chen, Y., & Li, S. (2020). Chitosan-Gentamicin Conjugate Hydrogel Promoting Skin Scald Repair. Marine Drugs, 18(5), 233. https://doi.org/10.3390/md18050233




